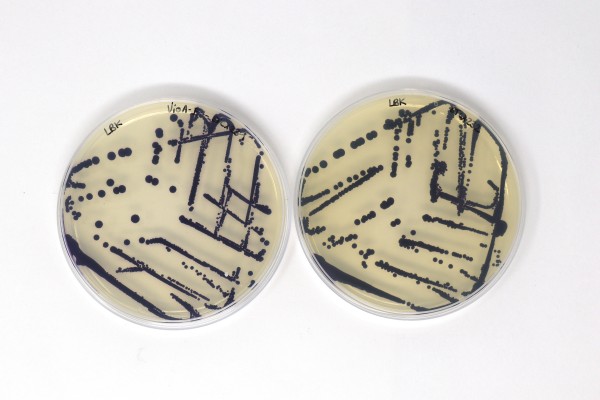
Roba este nuevo look de verano (son bacterias)

-
Roba este nuevo look de verano (son bacterias)
Las secreciones bacterianas podrían teñir tu futuro guardarropa, y eso sería una mejora. Esto se debe a que los textiles generalmente adquieren sus matices a partir de productos químicos tóxicos y las aguas residuales resultantes, cargadas de tintes, ácidos y formaldehído, destruyen los ríos, como los que rodean Daca, la capital de Bangladés. El tratamiento…
-

Retiran del mercado dos productos hidratantes Jergens por posible riesgo de bacterias
La compañía detrás de Jergens Ultra Healing Moisturizer está retirando un par de sus productos por la posible presencia de bacterias dañinas. Kao USA Inc. dijo que ciertos lotes de sus productos de 3 y 10 onzas podrían contener la presencia de Pluralibacter gergovia, que Kao describió como que generalmente representa “un riesgo médico pequeño…
-

Un test de heces para analizar las bacterias intestinales que predicen el cáncer de páncreas
Los humanos somos individuos, pero también un ecosistema. En nuestro interior, la mitad de las células nos pertenecen, pero la otra mitad es de una multitud de bacterias que nos habitan. Esas bacterias interactúan con nuestro organismo, nos ayudan a hacer la digestión e incluso influyen sobre nuestro estado mental. Se ha observado una composición…
-

Así será el apocalipsis en 2050: megaincendios y bacterias resistentes
En diversas ocasiones hemos hablado sobre el fin de la vida en el planeta Tierra, pero lo hemos hecho como algo muy lejano, que sucederá dentro de varios miles e incluso millones de años. Sin embargo, el borrador del Grupo Intergubernamental de Expertos sobre el Cambio Climático (IPCC) de la ONU, al que ha tenido…
-

Virus y bacterias: Características y diferencias
Las bacterias y los virus son algo común en la naturaleza. Aunque ambos comparten algunas características similares, lo cierto es que tienen notables diferencias entre ellas. Una de las cuestiones que en la que más se parecen ambos organismos es en su capacidad para provocar enfermedades para la especie humano o animal. ¿Qué diferencia las…
-

¿Cuáles son los tipos de reproducción en las bacterias?
¿Cómo se reproducen las bacterias? Sabemos de ellas que son microorganismos unicelulares que se encuentran presentes en multitud de superficies y organismos, pero ¿de qué manera se multiplican o cómo se extienden? Os explicamos a continuación qué es y cuáles son los tipos de reproducción en las bacterias. ¿Cuáles son los tipos de reproducción en…
-

Qué son las bacterias Gram Positivas y ejemplos
Las bacterias que parecen teñirse de púrpura bajo el microscopio cuando se usa la técnica de tinción de Gram se designan como gram positivas. Esto permite clasificar las bacterias y determinar rápidamente el tratamiento adecuado. En esta ocasión te vamos a explicar qué son las bacterias Gram positivas con algunos ejemplos. Qué son las bacterias…
-

Desinfectante para bacterias y gérmenes en el aire
Utilizando desinfectante es la mejor manera de proteger a su familia de las bacterias y los gérmenes del aire. Los desinfectantes son agentes antimicrobianos que se aplican para matar microorganismos. Aerosoles desinfectantes El desinfectante casero más eficaz es el blanqueador con cloro. Sin embargo, esto no es adecuado para combatir los gérmenes en el aire.…
-

¿Cuáles son las bacterias de la meningitis?
Cuando se inflaman las meninges, que son las membranas que rodean el cerebro y la médula espinal, estamos frente a una meningitis. Puede deberse a virus, parásitos, hongos, cáncer, alergias o bacterias. Cuando esta es la causa, la enfermedad puede ser muy grave y hasta mortal. Por eso es muy importante identificarla. Los más vulnerables…
-

¿Qué objetos y zonas del hogar acumulan más bacterias?
Las bacterias están muy presentes. En la cavidad bucal se encuentran muchos microorganismos que pueden transferirse al cepillo de dientes mientras se usan. Las toallas húmedas, cepillos de dientes sin escurrir o juguetes tirados por el suelo, son sitios magníficos para que crezcan los hongos y las bacterias. Conozcamos más sobre ellas ¿no? Las bacterias…